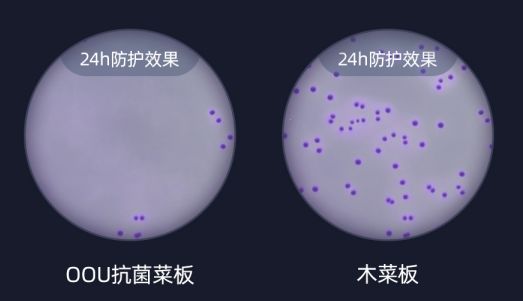
2000亿的细菌,哪种菜板不容易滋生细菌

如果有人问:你家里什么地方最脏?
99%的人可能都会回答“马桶”,
但大错特错,
最脏的其实是菜板。

平时蒜泥白切肉、焖大虾、地三鲜,
无论哪道家常美味,
必定都是在菜板上走过一轮的。

但有研究显示,
菜板上的细菌是马桶盖的200倍!
甚至还有几万大肠杆菌、200万葡萄球菌,
而这些脏东西正随着每顿饭
吃进你的肚子里。

尤其是有些发霉的菜板,
还含有国家一类致癌物
——黄曲霉素,
是引发肝癌的罪魁祸首!


所以有些人动不动就
腹泻、食物中毒、肠道感染,
很可能就是家里的旧菜板在作怪,
菜板上面的细菌正在悄无声息的
侵蚀你和你家人的健康。

那到底用什么菜板好呢?
用这款永不发霉,抗菌率达到99.9%的
OOU厨房多功能菜板啊。

长按二维码扫描购买
它采用日本进口材质,
能抗菌除臭、不发霉,不变形,可沥水,
还能磨刀、磨蒜泥、当果盘、
简直是菜板界的“劳斯莱斯”!

OOU多功能菜板
更是远销全球30多个国家和地区,
得到了欧盟的认可,
走进了欧洲人的厨房!

01
日本进口材质,
神奇的99.9%抗菌率!
艺姐曾看过这样一个实验:
用新菜板仅仅剁肉30秒,
1个小时后,
这块菜板就会滋生
每平方厘米82毫克的细菌!

新菜板都如此,
更别说那些陈年老菜板了,
每块都会含有大量的真菌和细菌,
轻则引发腹泻、皮肤病、呼吸道系统疾病,
重则还可能引起食物中毒和癌症。


普通的菜板主打便宜,
就是因为在材质上省钱!
而OOU菜板采用材质界的“爱马仕”
——日本进口Ag+!
能持续驱菌除臭,
抗菌率更是高达99.9%!

长按二维码扫描购买
我们还在实验室做了对比实验:
OOU抗菌菜板24h之内
几乎没有细菌,
而普通菜板细菌遍布!

而且普通菜板极易发霉,
对人体健康产生巨大伤害,
但OOU菜板久用也不发霉!

这里附上最新的
抑菌率99.9%的检测报告,
让你用的安心放心:

另外,有过厨房经验的都知道,
菜板极易留下密密麻麻的刀痕,
缝隙里满是残渣。

但我们的OOU菜板特别选取
TPR材质结合环保麦香料,
让菜板韧性更好密度更高,
不易开裂,也不会起屑,
更不会咬合刀刃。

切肉切菜切水果都毫无压力,
质量杠杠的,
用上10年都没问题。

采用好材质的菜板也不会出现渗色,
或者清洗不干净的情况。
看我们的办公室真实测试:
先用易染色的火龙果
涂满OOU菜板和普通菜板:

OUU菜板用纸巾一擦立刻干净无痕,
而普通菜板就惨了,
颜色渗了大半,难以恢复原样。


看吧,好的菜板必定是清洗方便的,
无论多少污渍,
OOU菜板用纸巾一擦,或者用水一冲,
立刻干净如新。

而且因为菜板
表面PP材质非常耐热,
连刚出炉的烤鸡也不在怕的哦。

要是有热汤、热锅,
也可拿菜板当做隔热垫 使用,
保护台面不被烫坏。

长按二维码扫描购买
这么完美的多功能菜板,
绝对是主妇必备神器,
能带给你一家人安心健康。

02
能磨蒜泥+能磨刀的菜板
=牛!
平时做菜,磨点蒜泥什么的,
先是切片再切丝、然后剁烂,
真是老大难了。

但这款菜板的隐藏惊喜
就是它自带磨蒜功能!

在菜板凸起处来回磨几下,
蒜泥轻松就做好啦!

有了蒜泥,
生蚝、基围虾的美味都翻倍~


不仅是能磨蒜,
其他土豆泥、萝卜泥,苹果泥想磨就磨,
做宝宝辅食也方便。

艺姐自己亲自动手磨了苹果泥,
两个字:好使!

这款菜板颜值又高,实力又爆表,
办公室妹子都想抱回家~

除此之外,
平时菜刀用久了总是会钝 ,
可现在磨剪子、磨刀的人几乎没有,
着实愁人。

但OOU多功能菜板其实还是
“一块可以磨刀的菜板”。

大刀小刀放磨刀处摩擦几下,
立刻就变锋利,
刃面也光亮如新。

长按二维码扫描购买
这样磨完的刀,
切菜自不必说,
切起肉来更是咻咻的:

让你再也不会有
“刀到用时方恨钝”的挫败感。
PS: 磨刀小窍门
用钝的菜刀, 可以先放在盐水中泡15分钟,
这样既磨得锋利,
又可延长菜刀的使用寿命。

好菜板当然好评如潮,
来看看真实的用户评价吧:




03
既可当沥水盘,
还可当果盘哟
平时餐碗、杯子不沥干水分的话,
只需4小时,
细菌就会繁衍上千,
8小时后更是翻倍暴增。

好在OOU多功能菜板还兼具沥水功能,
背后的凹凸水槽设计,
通风干爽,能轻松沥干水分。

高起的边缘帮助蓄水,
避免了台面湿漉漉的情况。


当然,凹槽也完美地满足了
“当果盘的需求”。

放水果、放茶具,
平稳又不溢水,
保持桌面、台面清洁,
太方便!太好用!

用完,水一冲,
脏水、污秽会顺着凹洞溜走,
菜板又变干干净净了。

长按二维码扫描购买
04
逆天防滑力,
秒杀普通地摊货!
切菜备菜的时候,
菜板打滑也是老大难的问题,
一不小心还会砸伤脚。

但OOU多功能菜板四周
采用TPR防滑防摔材料,
切菜磨刀根本不滑!

连放在凳子上,
也是稳稳的。

这样身兼数职的菜板,
实在可遇不可求!
而且大小是普通菜板的1.5倍大,
能满足基本日常需求。
可挂可立,
收纳也方便。

长按二维码扫描购买
OOU菜板 一共有大理石色、小麦色两款,
简洁北欧风,
样子高级有质感。
原价159
限时优惠仅售99元!
还不快把家里“有毒”的旧菜板扔了?
